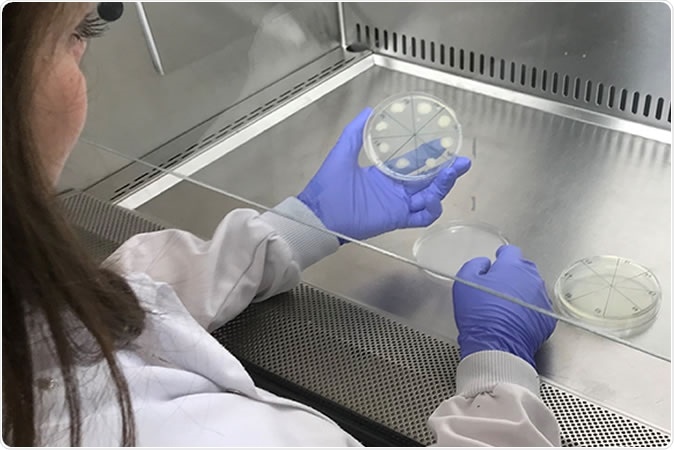
New treatment can completely kill a M. abscessus infection that can be deadly to cystic fibrosis

Researchers from Aston University and Birmingham Children’s Hospital have developed a new medication regimen that could successfully treat a bacterial infection that could prove fatal to patients with cystic fibrosis or bronchiectasis. The results of the new study were published in the latest issue of the journal Scientific Reports.
New treatment can completely kill a M. abscessus infection that can be deadly to cystic fibrosis
Cystic fibrosis is a chronic lung condition that is usually inherited and affects over ten thousand individuals in the United Kingdom. Bronchiectasis is another chronic lung condition that affects over two hundred thousand individuals in United Kingdom. Both of these conditions make a person prone to bacterial infections which are difficult to treat and usually can become fatal. In fact children with Cystis fibrosis are more at risk of early deaths compared to their healthy counterparts.
The team of researchers used a cocktail of three medications - amoxicillin and imipenem-relebactam for treatment of infections in patients with cystic fibrosis. The Mycobacterial Research Group of scientists showed that this combination could effectively kill bacteria that affect patients with chronic and deadly lung diseases such as cystic fibrosis and bronchiectasis. These infections caused by Mycobacterium abscessus are usually difficult to treat, they wrote. Mycobacteria family of bacteria is known to cause tuberculosis and leprosy. This strain of the bacteria can lead to serious and often life-threatening lung infections seen in children with cystic fibrosis or bronchiectasis, the researchers explained. The strain in addition is drug resistant and is difficult to treat with agents that normally kill the Mycobacterium species of bacteria.

Mycobacterium tuberculosis
For this study the team of researchers recruited 16 cystic fibrosis patients who were infected with the bacteria. Samples were collected from these patients before they were administered a regimen of medications containing amoxicillin-imipenem-relebactam. Results of the dose study also showed that minimal amount of the three drugs were enough to cure the infection in these patients. These low and effective doses also meant that the concoction was safe for the patients, wrote the researchers.
The team explained that Mycobacterium abscessus infections in these patients earlier necessitated not only hospitalization but also removed the patients from lung transplant wait lists as surgery could not be performed if a person was infected with this bacteria. Estimates reveal that 13 percent of cystic fibrosis patients suffer from this infection and could benefit from this treatment. They wrote that the treatment was effective as well as safe.
Study leader Dr Jonathan Cox, Lecturer in Microbiology, Aston University, in a statement said, “This new drug combination is a significant step forward for patients with cystic fibrosis that get infected with the deadly Mycobacterium abscessus bacteria. Our new drug combination is significantly less toxic than those currently used, and so far we have managed to kill every patient's bacterial isolate that we have received.”
He added in explanation, “This shows our drugs, when used in combination, are widely effective and could therefore make a huge difference to people whose treatment options are currently limited. Because amoxicillin is already widely available and imipenem-relebactam has just been approved for use by the Food and Drug Administration (FDA) in the US, these drugs are already available to clinicians. We therefore hope to start treating patients as soon as possible.”
According to the researchers the treatment would soon be tried on other patients of cystic fibrosis as well who were infected with this bacteria. They plan on comparing this combination of treatment with other antibiotics to see the superiority of either regimen of antibiotics as well as their comparative safety.
According to Dr Maya Desai, Consultant in Respiratory Paediatrics, Birmingham Children's Hospital, “This exciting development will significantly impact on the care of CF patients globally. It has been possible only with close collaboration between Aston University and Birmingham Children's Hospital both from a clinical research and financial point of view.”
Dr Paula Sommer, Head of Research at the Cystic Fibrosis Trust, also expressed her appreciation of the results of this study saying, “It's exciting that these lab-based studies investigating new antibiotic treatments for Mycobacterium abscessus infection are showing such promise and adding to our expanding knowledge of this devastating bug. Mycobacterium abscessus also known as NTM (non-tuberculous mycobacteria), is the most feared infection a person with cystic fibrosis can develop. Taking drugs to treat NTM can add to an already significant regime of daily treatments and take up to a year to clear infections. We look forward to a time when effective, short courses of treatment are available to treat NTM.”
Journal reference:
Lopeman, R.C., Harrison, J., Rathbone, D.L. et al. Effect of Amoxicillin in combination with Imipenem-Relebactam against Mycobacterium abscessus. Sci Rep 10, 928 (2020). https://doi.org/10.1038/s41598-020-57844-8. https://www.nature.com/articles/s41598-020-57844-8